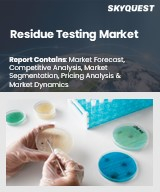

|
시장보고서
상품코드
1836925
잔류물 검사 시장 : 기술, 잔류물 유형, 최종사용자, 샘플 유형별 - 세계 예측(2025-2032년)Residue Testing Market by Technology, Residue Type, End User, Sample Type - Global Forecast 2025-2032 |
||||||
잔류물 검사 시장은 2032년까지 CAGR 7.00%로 98억 2,000만 달러로 성장할 것으로 예측됩니다.
| 주요 시장 통계 | |
|---|---|
| 기준 연도 2024년 | 57억 1,000만 달러 |
| 추정 연도 2025년 | 61억 2,000만 달러 |
| 예측 연도 2032 | 98억 2,000만 달러 |
| CAGR(%) | 7.00% |
공중 보건을 보호하고, 제품 품질을 보장하며, 강화된 규제 의무를 이행하기 위한 잔류물 검사의 진화하는 역할에 대한 간결한 방향성
잔류 농약 검사는 공중 보건 보호, 산업 품질 보증 및 환경 관리의 필수적인 기둥으로 실험실 실습과 규제 당국의 모니터링 모두에서 지속적인 개선이 요구되고 있습니다. 최근 몇 년 동안 과학의 발전과 규제 당국의 기대치 변화로 인해 더 빠르고, 더 민감하고, 더 추적 가능한 검사 방법에 대한 요구가 증가하고 있습니다. 이 소개에서는 이 분야를 재구성하고 있는 주요 요인의 틀을 제시하고, 현재 사용되고 있는 주요 분석 기술에 대한 개요를 제시하며, 이후 섹션에서 살펴볼 주제에 대한 기대치를 설정합니다.
분석 기술의 정교함은 분리와 검출을 결합하여 전례 없는 특이성과 처리량을 가진 기술로 전환하고 있습니다. 동시에 식품 제조, 의약품 제조, 환경 모니터링의 이해관계자들은 규제 당국의 정밀한 조사에서 방어할 수 있고 다양한 공급망에서 재현 가능한 결과를 필요로 하고 있습니다. 그 결과, 실험실은 하이엔드 장비에 대한 투자와 샘플 처리량, 데이터 무결성, CoC(Cain of Custody) 관행을 강화하는 업무 개선의 균형을 맞출 수 있습니다. 동시에 정책 입안자와 집행기관은 잔류허용기준을 강화하고 감시 프로그램을 확대하여 검사 의무의 범위와 빈도를 늘리고 있습니다.
이 소개서는 또한 시험소 관리자, 조달 책임자 및 정책 자문가들에게 실질적인 영향을 강조하고 있습니다. 즉, 전략적 장비 선택은 진화하는 잔류물 프로파일과 규제 우선순위에 부합해야 하며, 인력 계획은 전문 분석 기술에 대한 수요 증가를 인식하고, 데이터 관리 인프라는 안전한 집계, 후향적 분석 및 감사 대응이 가능한 보고가 가능한 데이터 관리 인프라를 구축해야 합니다. 이러한 전제를 바탕으로 본 보고서는 변화의 변화, 관세에 따른 영향, 경쟁 고려사항, 지역 역학, 경쟁 행동, 실행 가능한 권고사항, 조사 결과를 뒷받침하는 방법론의 엄밀성에 대한 분석을 진행합니다.
첨단 기술, 규제 강화, 디지털 통합이 잔류물 검사 관행과 업계의 기대치를 재정의하는 방법
잔류물 검사 환경은 기술의 비약적인 발전, 규제 강화, 이해관계자의 기대치 변화로 인해 변화의 시기를 맞이하고 있으며, 민감도, 속도, 통합된 데이터 인텔리전스를 우선시하는 새로운 검사 패러다임을 만들어내고 있습니다. 고해상도 장비는 이제 일상적으로 필요 시점 솔루션과 공존하고 있으며, 디지털 워크플로우를 통해 실험실에서 원시 분석 결과를 보다 높은 효율성과 추적성을 갖춘 실용적인 인사이트로 전환할 수 있게 되었습니다. 이 섹션에서는 검사 설계, 수행 및 해석 방법을 재조정하는 힘에 대해 설명합니다.
첫째, 첨단 분리 기술과 고해상도 검출을 결합한 하이브리드 접근 방식을 통해 분석 능력이 확대되어 다중 잔류물 패널과 새로운 오염물질의 후향적 스크리닝이 가능해졌습니다. 실험실에서는 표적 정량 및 비표적 발견이 모두 가능한 질량 분석 플랫폼의 채택이 증가하고 있으며, 이상 검출에서 발생원 파악까지의 경로가 단축되고 있습니다.
둘째, 자동화 및 모듈식 시료 전처리 시스템을 통해 처리량이 향상되고 작업자별 편차가 감소합니다.
셋째, 소프트웨어와 클라우드 기반 데이터 관리의 통합은 품질 보증 및 컴플라이언스 워크플로우를 변화시키고 있습니다. 실시간 분석, 자동화된 플래그 지정, 표준화된 보고 템플릿을 통해 의사결정 시간을 단축하고 규제 방어성을 강화할 수 있습니다. 마지막으로, 지속가능성 요건, 공급망 투명성, 청정 제품에 대한 소비자의 요구 등 보다 광범위한 산업 동향은 시험 서비스의 수직적 통합과 제조업체, 위탁 시험소, 규제 당국 간의 긴밀한 협력을 촉진하고 있습니다. 이러한 변화는 함께 검사기관과 공급업체가 신뢰할 수 있는 파트너로 남아있기 위해 충족시켜야 하는 새로운 성능에 대한 기대치를 만들어내고 있습니다.
누적 관세 조치가 잔류물 검사 가치사슬 전반에 걸쳐 조달 전략, 지역 역량 개발, 공급업체의 상업적 모델을 어떻게 변화시키고 있는지 이해합니다.
관세를 통해 시행되는 정책 개입과 무역 조치는 장비 조달, 소모품 조달, 국경 간 서비스 제공의 경제성을 변화시킴으로써 잔류 검사 생태계에 중대한 영향을 미칠 수 있습니다. 2025년에는 누적된 관세 조치로 인해 기존 공급업체와의 관계에 마찰이 발생하여 검사 기관과 제조업체는 조달 전략을 재검토하고 공급망을 다양화하며 위험을 줄이기 위해 특정 생산 활동을 현지화해야 합니다. 그 영향은 스티커 가격뿐만 아니라 리드 타임, 예비 부품의 가용성, 장기 서비스 계약의 실현 가능성에도 영향을 미칩니다.
그동안 중앙집중식 조달 모델을 취해왔던 연구실은 업무 중단을 피하기 위해 공급업체 수를 늘리고, 중요 소모품 재고를 확대하는 방식으로 대응하고 있습니다. 동시에 공급업체들은 경쟁력을 유지하기 위해 상업 모델을 조정하고, 번들 서비스 계약, 현지 재고 준비, 관세 관련 비용 상승을 상쇄할 수 있는 금융 옵션을 제공하고 있습니다. 이러한 적응은 실험실이 더 새롭고 더 높은 성능의 장비로 업그레이드하는 속도에 영향을 미치고, 관세가 총 취득 비용을 증가시킬 경우 자본 갱신 주기를 지연시킬 수 있습니다.
또한, 관세로 인한 변화는 공동검사 협정에도 파급효과를 가져옵니다. 중앙 집중식 고복잡도 분석을 위한 국경 간 시료 이동은 새로운 관리 부담과 비용에 직면하여 지역 검사 허브 및 역량 구축 이니셔티브의 개발을 촉진합니다. 이에 따라 규제 당국과 업계 컨소시엄은 중복 검사를 줄이고 감시 프로그램의 연속성을 유지하기 위해 조화로운 검사 방법과 검사 결과의 상호 승인을 점점 더 우선시하고 있습니다. 이러한 변화를 종합하면, 정책 주도의 시장 변동에 적응할 수 있는 탄력적인 조달 전략, 유연한 거래 조건, 전략적 파트너십의 중요성이 부각되고 있습니다.
종합적인 세분화를 통해 분석 기술, 잔류물 카테고리, 최종사용자 기대치 및 샘플 매트릭스가 실험실 투자 및 운영 설계를 결정하는 방법을 보여줍니다.
뉘앙스가 풍부한 세분화 프레임워크는 기술 선택, 우려되는 잔류물 유형, 최종사용자 요구 사항, 샘플 매트릭스가 실험실 구성 및 서비스 제공을 형성하는 방법을 보여줍니다. 전체 분석 기술에서 크로마토그래피는 여전히 기본적인 분리 기술이며, 가스 크로마토그래피는 휘발성 및 반휘발성 잔류물에 적합하고, 액체 크로마토그래피는 극성 화합물 및 열에 불안정한 화합물에 적합합니다. 질량 분석기는 일상적인 스크리닝에 적합한 단일 사중극자 장치부터 정확한 정량을 위해 설계된 탠덤 시스템, 비표적 워크플로우 및 후향적 데이터 마이닝을 가능하게 하는 고해상도 질량 분석기까지 다양한 검출기를 통해 분리 방법을 보완합니다. 면역분석은 대량 스크리닝을 위한 빠르고 비용 효율적인 대안을 제공하며, 분광법은 비파괴적이고 신속한 스크리닝 애플리케이션을 위한 틈새 역할을 수행합니다.
잔류 유형 프로파일은 방법의 선택과 규제상의 주의를 촉구합니다. 마크로라이드, 설폰아미드, 테트라사이클린과 같은 항생제는 식품 안전과 항균제 내성 감시를 관리하기 위해 고감도 검출이 필요합니다. 납이나 수은과 같은 중금속은 특별한 시료 분해 및 검출 프로토콜이 필요하며, 카르바마트, 유기염소, 유기인산염을 포함한 농약은 다양한 화학적 특성으로 인해 견고한 분리 및 선택적 검출이 요구됩니다. 마이코톡신은 저농도에서도 독성이 강하기 때문에 검출에 엄격한 한계가 있어 샘플 조제 단계의 면밀한 검증이 필요합니다.
최종사용자 세분화는 기대되는 서비스 수준과 보고 요구 사항을 결정합니다. 환경 기관은 표준화된 방법, CoC의 엄격성, 장기적인 비교 가능성을 우선시합니다. 가공업체에서 소매업체에 이르기까지 다양한 식음료 회사들은 신속한 처리, 공급업체 감사, 리콜 방지를 중요하게 생각합니다. 연구소 자체는 학술기관, 정부기관, 민간기업을 막론하고 연구 수준의 유연성과 업무 처리 능력의 균형을 맞추고 있습니다. 제네릭과 혁신기업을 포함한 제약사들은 규제 서류 요건을 충족하고 배치 릴리스의 무결성을 보장하는 검증된 방법을 중요시하고 있습니다.
샘플 유형에 대한 고려는 분석 워크플로우에 더 많은 영향을 미칩니다. 공기와 같은 기체 매트릭스는 특수한 샘플링 장비와 흡착제 기반의 추출 방식이 필요합니다. 오일이나 물과 같은 액체 매트릭스는 매트릭스 효과와 농축 또는 정화 공정의 필요성이라는 과제가 있습니다. 식품이나 토양을 포함한 고형물은 종종 다양한 구성으로 조정된 균질화, 추출 및 정화 프로토콜이 필요합니다. 이러한 세분화 차원을 결합하여 연구소가 배치해야 할 기술 역량을 정의하고 장비, 소모품, 직원 역량에 대한 투자 의사결정에 반영할 수 있습니다.
아메리카, 유럽, 중동 및 아프리카, 아시아태평양 각 지역의 규제 체계, 산업 집적, 인프라 우선순위가 전략적 요구를 어떻게 형성하고 있는가?
잔류물 검사 가치사슬 전반에 걸쳐 이해관계자들의 업무 우선순위와 경쟁 전략은 규제 체계, 산업 집적도, 인프라 능력의 차이를 반영하는 지역적 역학에 의해 형성됩니다. 미국 대륙에서는 소비자 보호와 환경 모니터링에 중점을 둔 규제가 일상적인 감시와 표적 조사 방법에 대한 수요를 자극하고 있습니다. 이 조합은 규제 준수와 브랜드 보호를 보장하기 위해 높은 처리량 선별 능력과 확인 분석 플랫폼에 대한 투자를 촉진하여 규제 준수와 브랜드 보호를 보장합니다.
유럽, 중동 및 아프리카의 경우, 규제의 복잡성과 이질성으로 인해 규제 통합을 위한 노력과 각 국가별 컴플라이언스에 특화된 틈새 서비스 제공업체들이 활약할 수 있는 기회가 생겨나고 있습니다. 특히 유럽에서는 엄격한 잔류규제를 유지하고 회원국 간 분석법 표준화를 지원하고 있어 분석법 검증과 시험소 간 비교 가능성에 대한 기대가 높아지고 있습니다. 중동 및 아프리카는 빠르게 성숙하고 있는 검사 시설 인프라와 역량 구축에 대한 수요가 혼재되어 있으며, 국경을 넘어서는 무역 흐름에 대응하는 지역적 우수성 센터의 가능성을 창출하고 있습니다.
아시아태평양은 주요 제조 거점이자 분석 서비스의 역동적인 시장으로 기능하고 있습니다. 급속한 산업화, 대량 식품 가공 및 강력한 수출 지향으로 인해 확장 가능한 검사 네트워크와 빠른 처리 시간이 중요해졌습니다. 이 지역의 여러 국가들은 점점 더 까다로워지는 수출입 요건에 대응하기 위해 시험소 현대화, 디지털 통합 및 인력 교육에 투자하고 있습니다. 각 지역에서는 공급망과 현지 정책 설정이 자본 집약적인 장비를 어디에 배치할지, 서비스 네트워크를 어떻게 구축할지, 기업이 어떤 컴플라이언스 전략을 우선순위에 둘지에 영향을 미치고 있습니다.
기술 리더십, 서비스 통합, 전략적 파트너십이 잔류농약 검사 기업 간 경쟁 우위를 결정하는 방식에 대한 인사이트
잔류물 검사 생태계에서 기업 간 경쟁력은 기술 리더십, 서비스 범위, 분석 및 규정 준수 문제를 모두 해결하는 통합 솔루션을 제공하는 능력에 의해 형성됩니다. 주요 장비 공급업체들은 총소유비용을 절감하고 높은 처리량 환경에서 채택을 가속화하기 위해 감지 감도, 자동화, 소프트웨어와 연동된 워크플로우의 지속적인 기술 혁신을 강조하고 있습니다. 소모품 및 시약 공급업체들은 일관성, 배치 간 반복성, 자동화된 시료 전처리 시스템과의 호환성을 두고 경쟁합니다.
계약 연구소는 신속한 턴어라운드와 감사에 대응할 수 있는 보고서 작성에 대한 방법론의 깊이를 결합하여 차별화를 꾀합니다. 교차 검증이 가능한 여러 잔류물 방법과 상호 운용 가능한 데이터 관리 시스템에 투자하는 기업은 고객이 원자재, 공정 내 관리, 완제품에 걸친 통합 검사 프로그램을 요구할 때 경쟁력을 확보할 수 있습니다. 자문 역량을 통합하는 서비스 제공업체는 고객이 규제 및 상업적 맥락에서 분석 결과를 해석할 수 있도록 지원하여 원시 분석 결과 이상의 부가가치를 창출할 수 있습니다.
장비 공급업체는 소프트웨어 개발자 및 서비스 연구소와 협력하여 고객의 도입 곡선을 용이하게 하는 번들 솔루션을 제공합니다. 동시에 소규모 전문 연구소는 고도의 복잡도 비표적 스크리닝, 맞춤형 분석법 개발 등 틈새 역량에 집중하여 생태계를 형성하고 있습니다. 업계 전반에 걸쳐 검증된 방법론, 신속하고 투명한 고객 커뮤니케이션, 확장 가능한 물류 제공 능력은 시장 리더와 추종자를 계속 차별화할 것으로 보입니다.
잔류물 검사에서 회복력, 규정 준수 및 장기적인 가치 창출을 강화하기 위해 실험실 운영자 및 기술 공급업체가 취할 수 있는 실용적이고 우선순위가 높은 조치들
기술적 타당성과 규제 탄력성을 유지하려는 업계 리더는 역량 투자, 공급망 탄력성, 이해관계자 참여에 걸친 일련의 협력적 행동을 추구해야 합니다. 향후 시험 역량을 유지하고 후향적 데이터 분석이 가능하도록 표적 정량화 및 비표적 스크리닝을 모두 제공하는 분석 플랫폼에 대한 투자를 우선시합니다. 처리량을 향상시키고, 인적 오류를 줄이고, 감사에 견딜 수 있는 데이터 트레일을 확보하기 위해 샘플 조제 및 실험실 정보 관리 시스템의 자동화로 하드웨어 업그레이드를 보완합니다.
주요 소모품 및 예비 부품의 조달처를 다변화하고, 무역 정책 전환에 따른 혼란을 완화하기 위해 지역별 창고 보관 및 위탁 모델을 검토합니다. 가능한 경우, 대체 공급업체를 인증하고, 업무 연속성을 유지하기 위해 안전 재고를 유지합니다. 자본 예산을 과도하게 확장하지 않고 생산능력을 확장하고 지역 규제 요건을 준수하기 위해 지역 계약 검사 시설과의 파트너십을 강화합니다.
규제 당국 및 표준화 단체와 적극적으로 협력하여 시험법 검증 관행 및 상호 승인 프레임워크를 마련하고, 관할권 간 중복 시험을 줄입니다. 복잡한 데이터세트에서 더 많은 가치를 창출할 수 있도록 분석 전문 지식과 데이터 과학 기술을 연결하는 맞춤형 교육 프로그램을 통해 인재 개발에 투자하고 있습니다. 마지막으로, 기업의 ESG 목표와 이해관계자의 기대에 부합하도록 용매 사용량을 최적화하고, 일회용 플라스틱을 최대한 줄이고, 에너지 소비를 모니터링하여 지속가능성 지표를 연구소 운영에 통합합니다.
전문가 인터뷰, 실험실 현장 관찰, 조사 결과를 검증하기 위한 엄격한 2차 조사를 결합한 다중 소스 조사 방법을 투명하게 설명합니다.
이 조사는 1차 정보와 2차 정보를 결합하고 1차 정보와 2차 정보를 엄격하게 방법론적으로 통합하여 결론이 확실하고 검증 가능하며 실행 가능한지 확인하기 위해 1차 정보와 2차 정보를 결합하여 엄격하게 통합합니다. 1차 자료에는 실험실 책임자, 규제 당국자, 업계 기술자와의 구조화된 인터뷰와 워크플로우, 장비 설치 위치, 시료 관리 관행을 관찰하기 위한 분석 시설 현장 방문이 포함됩니다. 이러한 현장 관찰과 더불어 전문가 패널 토론과 기술 검토를 통해 분석 방법 선택, 품질 관리 절차, 데이터 관리 과제에 대한 가정을 검증했습니다.
2차 조사는 동료 검토 문헌, 업계 백서, 규제 지침 문서, 공급업체 기술 사양서 등을 통해 기술 역량과 규제 동향을 파악했습니다. 데이터 삼각측량(triangulation)은 진술된 역량과 관찰된 실무의 차이를 조정하기 위해 사용되었으며, 문서화된 방법론의 실적과 과거 규제 조치에 대한 인터뷰 결과의 상호 검증과 같은 방법론적 안전장치가 마련되었습니다.
분석적 엄격성은 장비의 능력, 방법의 견고성, 운영의 확장성에 대한 표준화된 평가 기준을 사용하여 유지되었습니다. 공개된 데이터가 부족한 경우에는 한계가 인정되고, 그러한 경우에는 전문가의 판단이 해석의 지침이 되어 가정에 대한 투명성이 뒷받침되었습니다. 품질 보증 수단으로는 여러 차례의 편집자 검토, 전문가의 기술적 검증, 참가자의 기밀 유지 및 데이터 취급에 대한 윤리적 지침 준수 등이 있습니다.
기술적, 규제적, 업무적 요구사항을 통합하여 탄력적인 잔류농약 검사 시행을 위한 실용적인 로드맵을 제시하는 결론적 관점
요약하면, 잔류물 검사는 기술 능력, 규제 기대치 및 공급망 탄력성이 실험실과 서비스 제공업체 전체의 성능 요구 사항을 향상시키기 위해 수렴하는 변곡점에 있습니다. 분리 과학과 고해상도 검출의 발전으로 보다 종합적인 스크리닝과 후향적 분석이 가능해졌고, 자동화 및 디지털 워크플로우를 통해 처리량과 컴플라이언스 대응력이 향상되고 있습니다. 규제 강화와 무역 정책의 발전은 새로운 조달 및 운영 전략을 촉진하고 있으며, 지역적 역량과 방법론의 조화가 중요시되고 있습니다.
장비, 데이터 시스템, 인적자본에 대한 투자를 새로운 잔류물 프로파일과 컴플라이언스 우선순위에 맞게 적극적으로 조정하는 조직은 신뢰할 수 있고 방어 가능한 결과를 제공하고 집행 조치 및 상업적 사건에 신속하게 대응할 수 있는 유리한 입장에 서게 됩니다. 전략적 파트너십은 전문 연구소와 협력하든, 벤더와 솔루션을 통합하든, 능력의 배치를 가속화하고 자본의 제약을 완화할 수 있습니다. 마지막으로, 지속가능성과 회복탄력성을 검사 시설 운영에 통합하는 것은 운영 리스크를 줄이는 것뿐만 아니라 규제 당국, 고객, 투자자의 높아진 기대에 부응하는 것이기도 합니다.
이러한 결론을 종합하면 실용적인 로드맵을 제시할 수 있습니다. 즉, 이중 역량 기술에 대한 선택적 투자, 공급망 유연성 강화, 규제 당국과의 협력 강화, 분석 결과를 적시에 경영 의사결정에 반영할 수 있는 데이터 중심의 워크플로우를 구축하는 것입니다.
자주 묻는 질문
목차
제1장 서문
제2장 조사 방법
제3장 주요 요약
제4장 시장 개요
제5장 시장 인사이트
제6장 미국 관세의 누적 영향 2025
제7장 AI의 누적 영향 2025
제8장 잔류물 검사 시장 : 기술별
- 크로마토그래피
- 가스 크로마토그래피
- 액체 크로마토그래피
- 고속 액체 크로마토그래피
- 초고속 액체 크로마토그래피
- 면역측정
- 질량 분석
- 고분해능 질량 분석
- 싱글 사중극자 질량분석법
- 텐덤 질량분석법
- 분광법
제9장 잔류물 검사 시장 : 잔류물 종류별
- 항생제
- 매크로라이드
- 설폰아미드
- 테트라사이클린
- 중금속
- 납
- 수은
- 마이코톡신
- 농약
- 카바메이트
- 유기염소화합물
- 유기인화합물
제10장 잔류물 검사 시장 : 최종사용자별
- 환경 기관
- 연방정부 기관
- 지방 기관
- 식품 및 음료 회사
- 프로세서
- 소매업체
- 연구소
- 학술 연구실
- 정부 연구소
- 민간 연구소
- 제약회사
- 제네릭 기업
- 이노베이터 기업
제11장 잔류물 검사 시장 : 샘플 유형별
- 가스
- 공기
- 액체
- 기름
- 물
- 고체
- 음식
- 토양
제12장 잔류물 검사 시장 : 지역별
- 아메리카
- 북미
- 라틴아메리카
- 유럽, 중동 및 아프리카
- 유럽
- 중동
- 아프리카
- 아시아태평양
제13장 잔류물 검사 시장 : 그룹별
- ASEAN
- GCC
- EU
- BRICS
- G7
- NATO
제14장 잔류물 검사 시장 : 국가별
- 미국
- 캐나다
- 멕시코
- 브라질
- 영국
- 독일
- 프랑스
- 러시아
- 이탈리아
- 스페인
- 중국
- 인도
- 일본
- 호주
- 한국
제15장 경쟁 구도
- 시장 점유율 분석, 2024
- FPNV 포지셔닝 매트릭스, 2024
- 경쟁 분석
- Eurofins Scientific SE
- SGS Societe Generale de Surveillance SA
- Bureau Veritas SA
- Intertek Group plc
- ALS Limited
- Merieux NutriSciences Corporation
- Element Materials Technology Ltd
- TUV SUD AG
- UL Solutions, Inc.
- Charles River Laboratories
The Residue Testing Market is projected to grow by USD 9.82 billion at a CAGR of 7.00% by 2032.
| KEY MARKET STATISTICS | |
|---|---|
| Base Year [2024] | USD 5.71 billion |
| Estimated Year [2025] | USD 6.12 billion |
| Forecast Year [2032] | USD 9.82 billion |
| CAGR (%) | 7.00% |
A concise orientation to the evolving role of residue testing in safeguarding public health, assuring product quality, and meeting heightened regulatory obligations
Residue testing has become an indispensable pillar of public health protection, industrial quality assurance, and environmental stewardship, demanding continual refinement in both laboratory practice and regulatory oversight. In recent years, scientific advances and shifting regulatory expectations have converged to heighten demand for faster, more sensitive, and more traceable testing approaches. This introduction frames the core drivers reshaping the field, outlines the principal analytical technologies in contemporary use, and sets expectations for the themes explored in subsequent sections.
Analytical sophistication has migrated toward techniques that combine separation and detection with unprecedented specificity and throughput. At the same time, stakeholders across food production, pharmaceutical manufacturing, and environmental monitoring require results that are defensible under regulatory scrutiny and reproducible across diversified supply chains. Consequently, laboratories are balancing investments in high-end instrumentation with operational improvements that enhance sample throughput, data integrity, and chain-of-custody practices. Concurrently, policy makers and enforcement bodies are tightening permissible residue thresholds and expanding surveillance programs, which in turn increases the scope and frequency of testing obligations.
This introduction also highlights the practical implications for laboratory managers, procurement leaders, and policy advisors: strategic equipment choices must align with evolving residue profiles and regulatory priorities; workforce planning must acknowledge rising demand for specialized analytical skills; and data management infrastructures must be capable of secure aggregation, retrospective analysis, and audit-ready reporting. With these premises in place, the report proceeds to analyze transformational shifts, tariff-driven influences, segmentation insights, regional dynamics, competitive behavior, actionable recommendations, and the methodological rigor underpinning the findings.
How advanced technology, regulatory tightening, and digital integration are jointly redefining residue testing practices and industry expectations
The residue testing landscape is undergoing transformative shifts driven by technological breakthroughs, regulatory tightening, and shifts in stakeholder expectations, producing a new testing paradigm that prioritizes sensitivity, speed, and integrated data intelligence. High-resolution instrumentation now routinely coexists with point-of-need solutions, while digital workflows are enabling laboratories to transform raw analytical outputs into actionable insight with greater efficiency and traceability. This section outlines the forces that are recalibrating how tests are designed, executed, and interpreted.
First, analytical capability is expanding through hybrid approaches that pair advanced separation techniques with high-resolution detection, enabling multi-residue panels and retrospective screening for emerging contaminants. Laboratories increasingly adopt mass spectrometry platforms capable of both targeted quantitation and untargeted discovery, thus shortening the path from anomaly detection to source attribution.
Second, automation and modular sample-preparation systems are improving throughput and reducing operator-dependent variability, which is crucial as regulatory monitoring programs scale up.
Third, the integration of software and cloud-based data management is transforming quality assurance and compliance workflows. Real-time analytics, automated flagging, and standardized reporting templates reduce time to decision and enhance regulatory defensibility. Finally, broader industry trends-including sustainability requirements, supply chain transparency, and consumer demand for cleaner products-are incentivizing vertical integration of testing services and closer collaboration between manufacturers, contract laboratories, and regulators. Collectively, these shifts are erecting new performance expectations that laboratories and suppliers must meet to remain relevant and trusted partners.
Understanding how cumulative tariff actions are altering procurement strategies, regional capability development, and supplier commercial models across the residue testing value chain
Policy interventions and trade measures enacted through tariffs can materially influence the residue testing ecosystem by altering the economics of equipment sourcing, consumables procurement, and cross-border service delivery. In 2025, cumulative tariff dynamics have introduced friction into established supplier relationships, prompting laboratories and manufacturers to reassess procurement strategies, diversify supply chains, and localize certain production activities to mitigate risk. The effects extend beyond sticker price; they reshape lead times, spare-parts availability, and the feasibility of long-term service agreements.
Laboratories with historically centralized procurement models are responding by qualifying additional vendors and maintaining expanded inventories of critical consumables to avoid operational interruptions. Simultaneously, supplier firms are adjusting commercial models to preserve competitiveness, offering bundled service contracts, local stocking arrangements, and finance options that offset upfront tariff-related cost increases. These adaptations influence the pace at which laboratories can upgrade to newer, more capable instrumentation, and they can slow capital refresh cycles when tariffs amplify total acquisition cost.
Moreover, tariff-induced shifts have a ripple effect on collaborative testing arrangements. Cross-border sample transfers for centralized high-complexity analysis face new administrative burdens and costs, which encourage the development of regional testing hubs and capability-building initiatives. In response, regulatory agencies and industry consortia are increasingly prioritizing harmonized methods and mutual recognition of test results to reduce redundant testing and preserve continuity of surveillance programs. Taken together, these changes underscore the importance of resilient procurement strategies, flexible commercial terms, and strategic partnerships that can adapt to policy-driven market volatility.
Comprehensive segmentation showing how analytical technologies, residue categories, end-user expectations, and sample matrices collectively dictate laboratory investment and operational design
A nuanced segmentation framework reveals how technology choices, residue types of concern, end-user requirements, and sample matrices jointly shape laboratory configuration and service offerings. Across analytical technologies, chromatography remains a foundational separation technique, with gas chromatography appropriate for volatile and semi-volatile residues while liquid chromatography addresses polar and thermally labile compounds; within liquid chromatography, high performance and ultra high performance variants differ in throughput and solvent efficiency. Mass spectrometry complements separation methods with detectors ranging from single quadrupole devices suited to routine screening through tandem systems engineered for precise quantitation, and high-resolution mass spectrometry enabling untargeted workflows and retrospective data mining. Immunoassays present a rapid, cost-efficient alternative for high-volume screening, whereas spectroscopy serves niche roles for non-destructive and rapid screening applications.
Residue type profiles drive method choice and regulatory attention. Antibiotics such as macrolides, sulfonamides, and tetracyclines require sensitive detection to manage food safety and antimicrobial resistance surveillance. Heavy metals like lead and mercury necessitate specialized sample digestion and detection protocols, while pesticides including carbamates, organochlorines, and organophosphates demand robust separation and selective detection because of their diverse chemistries. Mycotoxins, given their potency at low concentrations, impose stringent limits on detection and require meticulous validation of sample preparation steps.
End-user segmentation determines service level expectations and reporting requirements. Environmental agencies prioritize standardized methods, chain-of-custody rigor, and longitudinal comparability. Food and beverage companies-spanning processors to retailers-focus on rapid turnaround, supplier audits, and recall avoidance. Laboratories themselves, whether academic, governmental, or private, balance research-grade flexibility with operational throughput. Pharmaceutical companies, including both generics and innovators, emphasize validated methods that meet regulatory dossier requirements and ensure batch-release integrity.
Sample type considerations further influence analytical workflows. Gaseous matrices such as air require specialized sampling apparatus and adsorbent-based extraction approaches. Liquid matrices like oil and water present challenges of matrix effects and the need for concentration or cleanup steps. Solids, including food and soil, often demand homogenization, extraction, and cleanup protocols tuned to diverse compositions. Combined, these segmentation dimensions define the technical capabilities laboratories must deploy and inform investment decisions across instrumentation, consumables, and staff competencies.
How regional regulatory regimes, industrial concentration, and infrastructure priorities are shaping distinct strategic imperatives across the Americas, EMEA, and Asia-Pacific
Regional dynamics shape the operational priorities and competitive strategies for stakeholders across the residue testing value chain, reflecting differences in regulatory regimes, industrial concentration, and infrastructure capacity. In the Americas, regulatory emphasis on consumer protection and environmental monitoring stimulates demand for both routine surveillance and targeted investigative testing; strong private-sector laboratory networks coexist with federal programs that set methodological standards and provide oversight. This combination drives investment in both high-throughput screening capabilities and confirmatory analytical platforms to ensure regulatory compliance and brand protection.
In Europe, Middle East & Africa, regulatory complexity and heterogeneity create opportunities for harmonization efforts as well as niche service providers who specialize in country-specific compliance. Europe, in particular, maintains rigorous residue controls and supports method standardization across member states, which elevates expectations for method validation and inter-laboratory comparability. The Middle East and Africa present a mix of rapidly maturing laboratory infrastructure and demand for capacity building, creating potential for regional centers of excellence that service transnational trade flows.
Asia-Pacific functions as both a major manufacturing base and a dynamic market for analytical services. Rapid industrialization, a high volume of food processing, and strong export orientation place a premium on scalable testing networks and rapid turnaround times. Several countries in the region are investing in laboratory modernization, digital integration, and workforce training to meet increasingly stringent import-export requirements. Across each region, supply chain considerations and local policy settings influence where capital-intensive instrumentation is deployed, how service networks are structured, and which compliance strategies firms prioritize.
Insights into how technology leadership, service integration, and strategic partnerships are determining competitive advantage among residue testing companies
Competitive dynamics among companies in the residue testing ecosystem are being shaped by technology leadership, service breadth, and the ability to deliver integrated solutions that address both analytical and compliance challenges. Leading instrument suppliers emphasize continuous innovation in detection sensitivity, automation, and software-linked workflows to reduce total cost of ownership and accelerate adoption in high-throughput environments. Consumables and reagent providers compete on consistency, batch-to-batch reproducibility, and compatibility with increasingly automated sample-preparation systems.
Contract laboratories differentiate by combining method depth with rapid turnaround and audit-ready reporting. Firms that invest in cross-validated multi-residue methods and interoperable data-management systems gain a competitive edge when customers demand consolidated testing programs spanning raw materials, in-process controls, and finished goods. Service providers that integrate advisory capabilities-helping clients interpret analytical results within regulatory and commercial contexts-create additional value beyond raw analytical output.
Partnerships and alliances are emerging as strategic tools: instrument vendors are collaborating with software developers and service laboratories to offer bundled solutions that ease the adoption curve for customers. At the same time, smaller specialist labs focus on niche capabilities, such as high-complexity untargeted screening or bespoke method development, forming ecosystems that larger organizations can tap through subcontracting. Across the industry, the ability to offer validated methods, fast and transparent client communication, and scalable logistics will continue to differentiate market leaders from followers.
Practical and prioritized actions that laboratory operators and technology suppliers can implement to enhance resilience, compliance, and long-term value creation in residue testing
Industry leaders seeking to maintain technological relevance and regulatory resilience should pursue a set of coordinated actions that span capability investment, supply chain resilience, and stakeholder engagement. Prioritize investments in analytical platforms that offer both targeted quantitation and untargeted screening to future-proof testing capacity and enable retrospective data analysis. Complement hardware upgrades with automation in sample preparation and laboratory information management systems to improve throughput, reduce human error, and ensure audit-ready data trails.
Diversify procurement sources for critical consumables and spare parts and consider regional warehousing or consignment models to mitigate disruptions caused by trade policy shifts. Where feasible, qualify alternative suppliers and maintain safety stock to preserve continuity of operations. Strengthen partnerships with regional contract laboratories to expand capacity without overextending capital budgets and to facilitate compliance with local regulatory requirements.
Engage proactively with regulators and standards bodies to align on method validation practices and mutual recognition frameworks that reduce redundant testing across jurisdictions. Invest in workforce development through targeted training programs that bridge analytical expertise and data-science skills, enabling teams to extract more value from complex datasets. Finally, incorporate sustainability metrics into laboratory operations by optimizing solvent usage, reducing single-use plastics where possible, and monitoring energy consumption to align with corporate ESG objectives and stakeholder expectations.
A transparent explanation of the multi-source research approach combining expert interviews, laboratory site observations, and rigorous secondary review to validate findings
This research synthesizes evidence from a methodologically rigorous combination of primary and secondary sources to ensure conclusions are robust, verifiable, and actionable. Primary inputs include structured interviews with laboratory directors, regulatory officials, and industry technologists, as well as site visits to analytical facilities to observe workflows, instrumentation footprints, and sample-management practices. These first-hand observations were complemented by expert panels and technical reviews to validate assumptions about method selection, quality control procedures, and data-management challenges.
Secondary research encompassed peer-reviewed literature, industry white papers, regulatory guidance documents, and supplier technical specifications to contextualize technology capabilities and regulatory trajectories. Data triangulation was used to reconcile differences between stated capabilities and observed practices, with methodological safeguards including cross-validation of interview findings against documented method performance and historical regulatory actions.
Analytical rigor was maintained through the use of standardized evaluation criteria for instrument capability, method robustness, and operational scalability. Limitations are acknowledged where public data were scarce, and in those instances expert judgment guided interpretation, supported by transparency about assumptions. Quality assurance measures included multiple rounds of editorial review, technical validation by subject-matter experts, and adherence to ethical guidelines for participant confidentiality and data handling.
Concluding perspectives that synthesize technological, regulatory, and operational imperatives into a pragmatic road map for resilient residue testing practices
In summary, residue testing is at an inflection point where technological capability, regulatory expectation, and supply chain resilience converge to elevate performance requirements across laboratories and service providers. Advances in separation science and high-resolution detection are enabling more comprehensive screening and retrospective analyses, while automation and digital workflows are improving throughput and compliance readiness. Regulatory tightening and trade policy developments are prompting new procurement and operational strategies, with an increased emphasis on regional capacity and method harmonization.
Organizations that proactively align investment in instrumentation, data systems, and human capital with emerging residue profiles and compliance priorities will be better positioned to provide reliable, defensible results and to respond rapidly to enforcement actions or commercial incidents. Strategic partnerships, whether through collaborations with specialized laboratories or integrated vendor-solution offerings, can accelerate capability deployment and mitigate capital constraints. Finally, embedding sustainability and resilience into laboratory operations will not only reduce operational risk but also respond to the growing expectations of regulators, customers, and investors.
Taken together, these conclusions point to a practical road map: invest selectively in dual-capability technologies, strengthen supply chain flexibility, cultivate regulatory engagement, and build data-centric workflows that translate analytical outputs into timely management decisions.
Table of Contents
1. Preface
- 1.1. Objectives of the Study
- 1.2. Market Segmentation & Coverage
- 1.3. Years Considered for the Study
- 1.4. Currency & Pricing
- 1.5. Language
- 1.6. Stakeholders
2. Research Methodology
3. Executive Summary
4. Market Overview
5. Market Insights
- 5.1. Expansion of high-throughput mass spectrometry platforms to accelerate pesticide residue screening in food production facilities
- 5.2. Adoption of portable point of use residue testing devices to improve on farm pesticide monitoring
- 5.3. Integration of artificial intelligence driven spectral analysis software for rapid residue identification and quantification
- 5.4. Implementation of green and sustainable sample preparation techniques to minimize solvent usage in residue testing laboratories
- 5.5. Rising regulatory pressure on lowering maximum residue limits leading to updated testing protocols and instrumentation upgrades
- 5.6. Surge in demand for PFAS residue detection services driven by expanded regulatory mandates across industrial and agricultural sectors
6. Cumulative Impact of United States Tariffs 2025
7. Cumulative Impact of Artificial Intelligence 2025
8. Residue Testing Market, by Technology
- 8.1. Chromatography
- 8.1.1. Gas Chromatography
- 8.1.2. Liquid Chromatography
- 8.1.2.1. High Performance Liquid Chromatography
- 8.1.2.2. Ultra High Performance Liquid Chromatography
- 8.2. Immunoassay
- 8.3. Mass Spectrometry
- 8.3.1. High Resolution Mass Spectrometry
- 8.3.2. Single Quadrupole Mass Spectrometry
- 8.3.3. Tandem Mass Spectrometry
- 8.4. Spectroscopy
9. Residue Testing Market, by Residue Type
- 9.1. Antibiotics
- 9.1.1. Macrolides
- 9.1.2. Sulfonamides
- 9.1.3. Tetracyclines
- 9.2. Heavy Metals
- 9.2.1. Lead
- 9.2.2. Mercury
- 9.3. Mycotoxins
- 9.4. Pesticides
- 9.4.1. Carbamates
- 9.4.2. Organochlorines
- 9.4.3. Organophosphates
10. Residue Testing Market, by End User
- 10.1. Environmental Agencies
- 10.1.1. Federal Agencies
- 10.1.2. Local Agencies
- 10.2. Food And Beverage Companies
- 10.2.1. Processors
- 10.2.2. Retailers
- 10.3. Laboratories
- 10.3.1. Academic Laboratories
- 10.3.2. Government Laboratories
- 10.3.3. Private Laboratories
- 10.4. Pharmaceutical Companies
- 10.4.1. Generic Companies
- 10.4.2. Innovator Companies
11. Residue Testing Market, by Sample Type
- 11.1. Gas
- 11.1.1. Air
- 11.2. Liquid
- 11.2.1. Oil
- 11.2.2. Water
- 11.3. Solid
- 11.3.1. Food
- 11.3.2. Soil
12. Residue Testing Market, by Region
- 12.1. Americas
- 12.1.1. North America
- 12.1.2. Latin America
- 12.2. Europe, Middle East & Africa
- 12.2.1. Europe
- 12.2.2. Middle East
- 12.2.3. Africa
- 12.3. Asia-Pacific
13. Residue Testing Market, by Group
- 13.1. ASEAN
- 13.2. GCC
- 13.3. European Union
- 13.4. BRICS
- 13.5. G7
- 13.6. NATO
14. Residue Testing Market, by Country
- 14.1. United States
- 14.2. Canada
- 14.3. Mexico
- 14.4. Brazil
- 14.5. United Kingdom
- 14.6. Germany
- 14.7. France
- 14.8. Russia
- 14.9. Italy
- 14.10. Spain
- 14.11. China
- 14.12. India
- 14.13. Japan
- 14.14. Australia
- 14.15. South Korea
15. Competitive Landscape
- 15.1. Market Share Analysis, 2024
- 15.2. FPNV Positioning Matrix, 2024
- 15.3. Competitive Analysis
- 15.3.1. Eurofins Scientific SE
- 15.3.2. SGS Societe Generale de Surveillance SA
- 15.3.3. Bureau Veritas SA
- 15.3.4. Intertek Group plc
- 15.3.5. ALS Limited
- 15.3.6. Merieux NutriSciences Corporation
- 15.3.7. Element Materials Technology Ltd
- 15.3.8. TUV SUD AG
- 15.3.9. UL Solutions, Inc.
- 15.3.10. Charles River Laboratories